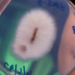
Fim da pobreza? Fungo que transformam mineiras em ouro puro foi descoberto e pode ser cultivado em casa

Tendo em vista as ofertas, o ato de comprar camarão deve ser seguido com atenção, para que as pessoas não se prejudiquem.
São muitas aquelas que usam o crustáceo para fazer diversas receitas, nas quais ele pode ser valorizado quanto à alimentação.
Na embalagem, especificamente no rótulo do produto, existem informações importantes, e elas precisam ser conferidas.
Evite ser surpreendido
Por meio de uma pesquisa realizada pela Associação Brasileira de Defesa do Consumidor (Proteste), as empresas que fabricam o camarão não mostram exatamente a questão de seu peso, tentando contornar isso pelos valores. Sendo assim, é possível que haja ao menos 10% de gelo.
O processo que se determina para o camarão se dá justamente por sua conservação. Além disso, algumas pessoas colocam-no em recipientes, podendo ser consumido da maneira que agradar, retirando a cabeça. Mas é fundamental que o público tenha plena noção do que está adquirindo. Sendo assim, na embalagem, eles apresentam somente o peso líquido, o que não é suficiente.
De acordo com os responsáveis pela pesquisa, o Inmetro retrata, por meio de uma portaria, aquilo que deve ser seguido para apresentar o peso dos pescados. Porém, não existe exatamente uma legislação capaz de apresentar às pessoas a que se refere o peso, sendo ele o que apresenta diferença quanto ao camarão com gelo.
Se tratando daquilo que passou pela pesquisa, foram vistos alguns camarões que não deveriam ser comprados e, muito menos, consumidos pelas pessoas. Diante da apresentação da Proteste, o direcionamento seguinte é para a Secretaria Nacional de Aquicultura, que age conforme as normas, incluindo a Anvisa, que fiscaliza.
Portanto, é fundamental analisar essa questão na embalagem do camarão, porque os consumidores precisam estar informados quanto ao que compram. Sendo assim, o consumo também deve ser consciente, de modo que as receitas sejam feitas com o propósito de apreciar o produto.